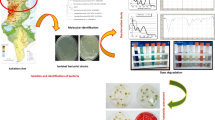

Abstract
Synthetic dyes pose a significant environmental threat due to their complex structures and resistance to microbial degradation. S. commune 15R-5-F01 exhibited over 96% degradation efficiency of Methyl Red in a medium with 100 mg L−1 Methyl Red within 3 h. The fungus demonstrated adaptability to various environmental conditions, including different pH levels, temperatures, oxygen concentrations, salinity, and heavy metals. S. commune 15R-5-F01 is capable of achieving repeated cycles of Methyl Red reduction with sustained degradation duration minimum of 6 cycles. It showed a maximum Methyl Red biodegradation capacity of at least 558 mg g−1 dry mycelia and a bioadsorption capacity of 57 mg g−1. Gas chromatography–mass spectrometry analysis confirmed the azo reduction of Methyl Red into N,N-dimethyl-p-phenylenediamine and 2-aminobenzoic acid. Enzymatic activity assays indicated the involvement of lignin peroxidases, laccases, and manganese peroxidase in the biodegradation process. Phytotoxicity tests on Triticum eastivum, Oryza sativa, and Vigna umbellata seeds revealed reduced toxicity of the degradation products compared to Methyl Red. This study identifies S. commune 15R-5-F01 as a viable candidate for the sustainable degradation of synthetic dyes in industrial wastewater.
Similar content being viewed by others
Explore related subjects
Discover the latest articles, news and stories from top researchers in related subjects.Avoid common mistakes on your manuscript.
Introduction
Water pollution is a global concern, significantly impacted by various industries, such as textiles, tanning, paper, cosmetics, biomedicine, and food processing (Karm et al. 2022). A substantial portion of water pollutants originates from azo dyes and anthraquinone dyes, which constitute approximately 60% and 15% of dye classes, respectively (Routoula and Patwardhan 2020). Notably, about 10–15% of these dyes produced during industrial processes exhibit resistance to water, sweat, light exposure, oxidizing agents, and microbial activity (Lellis et al. 2019). Even at low concentrations, these dyes remain visible in water, posing significant threats to water quality due to their color, toxicity, carcinogenicity, and mutagenicity (Guo et al. 2020). Therefore, it is crucial to effectively decolorize wastewater before discharging it into the environment.
Various methods have been explored for the treatment and decontamination of industrial wastewater, including physical, chemical, and biological systems. Physical and chemical processes such as adsorption, chemical precipitation, photolysis, oxidation, reduction, and electrochemical treatment have been widely used for decolorization (Al-Najar et al. 2021; Praveen et al. 2022; Sehar et al. 2021; Younis and Loucif 2021). However, these methods have limitations often suffer from drawbacks such as high cost, inefficiency, and the generation of toxic sludge and intermediate waste products (Kurade et al. 2011). In contrast, biological methods provide a more cost-effective, eco-friendly, and efficient approach by utilizing naturally occurring organisms such as fungi, bacteria, yeast, algae, and plants, or their enzymes/secondary metabolites (Chau et al. 2023; Kumar et al. 2018; Shi et al. 2021). Biodegradation of dyes in wastewater involves the action of oxidases such as tyrosinases, laccases, peroxidases, veratryl alcohol oxidase, and azoreductases (An et al. 2023; Hamdi et al. 2022; Masarbo and Karegoudar 2022).
Schizophyllum commune is a widely distributed basidiomycete fungus known for its remarkable ability to secrete various hydrolytic enzymes, including xylanases and endoglucanases (Gautam et al. 2018). Additionally, the presence of numerous protein-coding genes for ligninolytic enzymes suggests that S. commune is highly effective in degrading various synthetic dyes (Kumar et al. 2022). Our previous study revealed that S. commune is a dominant fungal species in subseafloor sediments with coal deposits. It exhibits unique genetic, metabolic, and anaerobic adaptation mechanisms within the deep subseafloor biosphere (ul Arifeen et al. 2022; Huang et al. 2022; Liu et al. 2022) and has a significant ability to degrade PHAs anaerobically, supporting its growth (ul Arifeen et al. 2022).
The aim of this study is to investigate the potential of the subseafloor fungus S. commune 15R-5-F01 for degrading Methyl Red (MR), a synthetic dye known for its environmental persistence. Specifically, this research explores the fungus's ability to degrade MR under various environmental conditions, analyzes the degradation products, evaluates their biological toxicity, and assesses the potential reuse of fungal biomass in the degradation process. The findings highlight S. commune 15R-5-F01 as a promising candidate for sustainable bioremediation of industrial wastewater contaminated with synthetic dyes, addressing a critical environmental challenge.
Materials and methods
Chemicals, media, and fungi
Methyl Red (MR) and media such as yeast extract glucose medium (YG) and yeast extract glucose agar medium (YGA) were obtained from Nanjing Wanqinghuabo Company. Additional chemicals were purchased from Sigma-Aldrich Chemical Company. The fungi used in this study, including Eurotium rubrum 3R-3-F02, Aspergillus versicolor 7R-1-F02, Eutypalla scoparia 8L-9-F01, Penicillium citrinum 15R-2-F01, S. commune 15R-5-F01, Chaetomium madrasense 23R-3-F01, Bjerkandera fumosa 26R-5-F09, Cladosporium sphaerospermum 32R-1-F01, Aspergillus sydowii 32R-1-F02, were previously isolated from ~ 2.0 km coal-bearing subseafloor sediments and maintained on Potato Dextrose Agar (PDA) at 4 °C in our laboratory (Liu et al. 2017). Agar plugs (1.0 × 1.0 × 0.3 cm3) were excised from the periphery of fungal colonies on PDA plates and transferred to a 500 mL conical flask containing 250 mL Potato Dextrose (PD) medium. The flask was incubated at 30 °C with shaking at 150 rpm for 5–7 days, after which the mycelia were harvested by filtration and rinsed with sterilized water for subsequent MR degradation tests.
Optimization of culture conditions for Methyl Red degradation by fungus
MR degradation experiments were conducted in 250-mL conical flasks, each containing 100 mL of YG supplemented with 100 mg L−1 of MR. One gram of fungal mycelia (~ 90 mg dry weight) was inoculated into each flask, followed by cultivation at 30 °C with agitation at 150 rpm. Biological and non-biological control groups were included to ensure experimental validity. To measure MR degradation, cultures were centrifuged at 12,000 rpm at 4 °C for 10 min at 4°C after 3 h of incubation and the concentration of MR in solution was measured at 420 nm by spectrophotometry (Ikram et al. 2022). The degradation efficiency of fungi was determined through the following equation:
where MRcontrol is the MR in uninoculated sample and MRsample is the MR content in the inoculated sample. Each experimental conditions were replicated at least three times to ensure statistical significance.
The influence of various culture conditions on MR degradation was investigated by varying single factors: (1) Temperature: Ranging from 15 to 45 °C. (2) pH: Adjusted from 1 to 10 using HCl and NaOH. (3) MR Concentration: Tested from 50 mg L−1 to 1,000 mg L−1. (4) Metal Ions: Added at 0.1 mmol L−1 concentration for Mn2+, Fe3+, Pb2+ and Ni+, Ba2+, Ca2+, Co2+, Hg2+, Ag+, Cu2+, Cd2+, and Al3+. (5) Salinity: Varied from 0 to 21% NaCl. (6) Oxygen levels: Including aerobic and anaerobic created following the method described by ul Arifeen et al. (2022).
Additionally, the degradation capability of MR by S. commune 15R-5-F01was evaluated using continuous batch shaking cultures. Each batch culture contained 100 mg L−1 MR and was incubated at 30°C with agitation at 150 rpm. Degradation efficiency was measured hourly over a period of 3 h. Following each measurement, mycelia were harvested by centrifugation, washed with sterile water, and subsequently transferred to fresh MR-containing YG for six consecutive cycles.
Fungal adsorption and biodegradation of Methyl Red in YG
To investigate the fungal adsorption of MR, experiments were conducted in 250-mL conical flasks containing 100 mL YG with a final MR concentration from 100 to 1000 mg L−1. The flasks were inoculated with 1 g inactivated mycelia (autoclaving 45 min at 121 °C) and cultured at 30 °C with agitation at 150 rpm (ul Arifeen et al. 2022). Biological and non-biological controls without dye or mycelium supplementation, respectively, were used as negative controls. Subsequently, the culture broth was centrifuged at 12,000 rpm at 4 °C for 10 min, resulting in the supernatant being measured to calculate the adsorption efficiency of MR. The biodegradation amount was calculated by deducting the amount of bioadsorption in the solution from the total reduced amount.
Enzymatic activity assays for manganese peroxidase, lignin peroxidase, and laccase
The activity of manganese peroxidase (MnP) was determined by measuring the change in absorbance at 240 nm (ΔOD240 nm). The assay mixture consisted of 1.70 mL of sodium tartrate buffer (pH 3.0, 0.24 mol L−1), 0.05 mL of MnSO4 (0.40 mol L−1), 0.2 mL of appropriately diluted enzyme solution, and 0.05 mL of H2O2 (0.016 mol L−1). One unit of MnP activity was defined as a 0.1 increase in ΔOD 240 nm per minute (Xu et al. 2001).
The activity of lignin peroxidase (LiP) was assayed by monitoring the change in absorbance at 310 nm (ΔOD310 nm) corresponding to the oxidation of veratryl alcohol to veratraldehyde. The assay mixture contained 2.7 mL reaction solution (including 0.80 mmol L−1 sodium tartrate buffer, pH 3.0), 0.3 mL appropriately diluted enzyme solution, and 0.05 mL of H2O2 (0.016 mol L−1). One unit of LiP activity was defined as the amount of enzyme required to produce 1 μmol veratraldehyde per minute (Xu et al. 2001).
Laccase (Lac) activity in the supernatant obtained after culture centrifugation was assayed by monitoring ABTS oxidation at 420 nm. The reaction mixture contained enzyme extract, 20 mmol L−1 citrate phosphate buffer (pH 4.5), and 10 mmol L−1 ABTS (Jasińska et al. 2015).
Analysis of Methyl Red degradation products
Gas chromatography-mass spectrometry (GC–MS) analysis was employed to detect the degradation products of MR. The supernatant (100 mL) was collected by centrifugation at 12,000 rpm for 10 min at 4 °C. The product was extracted with ethyl acetate three times. The combined extracts were dried and then dissolved in 10 mL of chromatographic-grade methanol for GC–MS analysis (Guo et al. 2021). Biological and non-biological controls without dye supplementation were processed identically. The spectra were analyzed using Agilent MSD ChemStation software with reference to NIST08 mass spectrometry library.
Toxicity assessment of Methyl Red degradation products using seed germination assays
To assess the toxicity of MR degradation products, seed germination excrements were performed using Triticum eastivum, Oryza sativa, and Vigna umbellata seeds (He et al. 2018; Singh and Dwivedi 2020). The supernatant obtained after 3 h of degradation, along with deionized water and a 100 mg L−1 MR solution as controls, was filtered through a 0.22 μm Millipore filter. This filtrate was used to spray 10 seeds placed on filter paper in petri dishes. The dishes were incubated at 30 °C, and after 6 days, the germination rate, radicle and plumule length, and wet weight of the seeds were measured (Bankole et al. 2018). Each treatment was replicated five times.
Statistical analysis
All experiments were performed in triplicate unless otherwise specified. Significance between samples was determined using one-way analysis of variance (ANOVA). GraphPad Prism version 9.0.0 was utilized for statistical analyses. Results with a p-value < 0.05 were considered statistically significant.
Results and discussion
Methyl Red degradation efficiency of subseafloor fungal species
The nine subseafloor fungal species tested displayed varying efficiencies in degrading MR (Fig. 1). Among them, S. commune 15R-5-F01 exhibited the highest degradation efficiency at 99%, followed by E. scoparia 8R-9-F01 and C. madrasense 23R-3-F01 with degradation efficiency around 96%. P. citrinum 15R-2-F01, B. fumosa 26R-5-F09, and C. sphaerospermum 32R-1-F01 demonstrated degradation efficiencies of approximately 86%. The lowest degradation efficiencies were observed in A. sydowii 32R-1-F02 (69.77%), A. versicolor 7R-1-F02 (59.49%), and E. rubrum 3R-3-F02 (47.98%). Given the exceptional MR degradation efficiency of S. commune 15R-5-F01, further investigations were conducted to elucidate the degradation conditions and mechanisms of this fungus.
Degradation efficiency of MR by nine subseafloor fungal strains. The fungal strains include Eurotium rubrum 3R-3-F02, Aspergillus versicolor 7R-1-F02, Eutypalla scoparia 8L-9-F01, Penicillium citrinum 15R-2-F01, S. commune 15R-5-F01, Chaetomium madrasense 23R-3-F01, Bjerkandera fumosa 26R-5-F09, Cladosporium sphaerospermum 32R-1-F01, and Aspergillus sydowii 32R-1-F02. Degradation efficiency was measured after 3 h by S. commune 15R-5-F01 cultured in YG supplemented with 100 mgL−1 MR. Lowercase letters represent the significant difference in degradation efficiency among the fungal strains (p < 0.05)
Environmental factors influencing Methyl Red degradation by S. commune 15R-5-F01
Oxygen
To investigate the impact of oxygen on MR degradation, S. commune 15R-5-F01 was inoculated in YG medium with 100 mg L−1 MR and subjected to aerobic and anaerobic condition. As shown in Fig. 2a, the strain displayed effective MR degradation in both environments, with no significant difference in degradation efficiency (p > 0.05). Approximately 75% MR was degraded within one hour, and near-complete degradation was achieved after three hours. The consistent degradation efficiency suggests that S. commune may possess unique properties facilitating the degradation of MR. Previous studies have shown certain fungi can degrade dyes under aerobic (e.g., Pseudomonas aeruginosa (Ikram et al. 2022), Galactomyces geotrichum Saccharomyces cerevisiae (Guo et al. 2019)), or anaerobic conditions (e.g., Aspergillus niger (Asses et al. 2018), Trichoderma tomentosum (Góralczyk-Bińkowska et al. 2021), but none have demonstrated such versatility in both conditions. Therefore, S. commune emerges as a promising candidate for bioremediation processes targeting MR, providing novel insights into fungal dye degradation under various environmental conditions. Notably, all subsequent experiments in this study were conducted under aerobic conditions due to the relative experimental ease compared to anaerobic conditions.
Degradation of MR by S. commune 15R-5-F01 under different conditions: aerobic/anaerobic (a), salinity (b), metal ions (c), and MR concentrations (d). Degradation efficiency of MR by S. commune 15R-5-F01 cultured in YG under varying single factors. Letters a to d represent the following varying factors: a oxygen (aerobic and anaerobic conditions), b salinity (0–21% NaCl), c metal ions (0.1 mmol L−1), and d MR concentrations (50–1000 mg L−1). Degradation efficiency was measured after 3 h of incubation. Lowercase letters indicate significant differences in degradation efficiency among the treatments of each factor (p < 0.05). The inoculation amount of each group was 1 g of wet weight mycelium, with a corresponding dry weight of approximately 90 mg
pH
The initial pH of the culture medium significantly influenced MR degradation by S. commune 15R-5-F01 (Table 1). Optimal degradation efficiency was observed within a pH range of 5.0 to 8.0, with pH 6 being the most favorable. Remarkably, even under highly acidic (pH 1.0–4.0) or strong alkaline conditions (pH 9.0, 10.0), S. commune 15R-5-F01 displayed considerable MR degradation capability. The pH level profoundly affects the degradation of dyes by microorganisms, primarily due to its impact on the transport of dye molecules across cell membranes—a crucial step in biodegradation (Marvi-Mashhadi et al. 2022). The ability of S. commune 15R-5-F01 to degrade MR over a wide range of pH highlights its significant potential for remediating MR-contaminated environments and suggests broader application prospects.
Temperature
Temperature critically influences MR degradation by microorganisms (Marvi-Mashhadi et al. 2022). S. commune 15R-5-F01 demonstrated variable efficiency in MR degradation at different temperatures, with the highest efficiency observed at 30°C (97.4%), followed by 37°C (91.5%), 22°C (83.0%), 45°C (65.5%), and 15°C (54.7%) (Table 1). The results underscore the extensive temperature adaptability of S. commune 15R-5-F01 in MR degradation. The strain performs optimally at moderate temperatures around 30°C while maintaining degradation capability at higher and lower temperatures, albeit with reduced efficiency. Compared to other microorganisms (Maniyam et al. 2020), S. commune 15R-5-F01 demonstrates superior temperature adaptability, achieving higher efficiency and shorter degradation times across various temperature ranges. The application of S. commune 15R-5-F01 in industrial wastewater treatment could reduce temperature requirements, thereby lowering overall implementation costs.
Salinity
The degradation efficiency of S. commune 15R-5-F01 in degrading MR is highly influenced by salinity levels (Fig. 2b). At salinities below 5%, the MR degradation efficiency reaches an impressive ~ 98%, with no significant difference observed among different salinities. However, as salinity increases, the degradation efficiency significantly declines (p < 0.05). For instance, at 9% salinity, the degradation efficiency drops to 87%, and even at 15% salinity, it remains above 70%. However, at 21% salinity, degradation rate reduces to only 56%. Previous studies have also highlighted the significant impact of salinity on microbial degradation efficiency of MR (Haque et al. 2022; Maniyam et al. 2020). Although the salinity affects the degradation efficiency of S. commune 15R-5-F01, it consistently exhibits relatively higher degradation efficiency within shorter timeframes at different salinity levels, indicating its potential for practical applications in MR degradation with high salt content.
Metal ions
The degradation capacity of S. commune 15R-5-F01 towards MR is significantly influenced (p < 0.05) by the concentration of metal ions (Fig. 2c). Notably, the presence of Zn2+ enhances MR degradation efficiency to approximately 100%, indicating a remarkable improvement compared to degradation without metal ions. On the other hand, Mn2+ and Fe3+ have minimal effects, resulting in lower degradation rates. In the presence of other metal ions, degradation efficiency decreases to around 80%—90%. Among the studied metal ions, Cd2+ exhibits the most pronounced effect, leading to a degradation efficiency of only 79%. Previous studies have demonstrated that the presence of Cu2+, Ba2+, Ca2+, Co2+, Hg2+, Cd2+, Pb2+, and Cr3+ and other metal ions not only inhibits cell growth (Kumar et al. 2018), but also affects dye degradation by reducing the rate of carbohydrate transport (Telke et al. 2009). The results of this study highlight the strong activity of S. commune 15R-5-F01 in degrading MR, even in the presence of heavy metal ions. This unique property enables efficient degradation of industrial dye wastewater containing various metal ions, providing a new biological resource for treating dye wastewater.
Methyl Red concentrations
The concentration of MR significantly impacts the degradation efficiency of S. commune 15R-5-F01 (p < 0.05). Within a range of 50–500 mg L−1 concentration, the fungus achieves over 90.9% degradation within 3 h. However, as MR concentration exceeds 500 mg L−1, the degradation efficiency gradually decreases (Fig. 2d). This decline may be attributed to factors such as loss of cell viability, reduced reproduction rate, weakened enzyme activity, or inherent toxicity of the dye itself (Saratale et al. 2011; Solís et al. 2012). Nevertheless, it is important to note that S. commune 15R-5-F01 demonstrates not only high MR degradation activity but also strong tolerance to high MR concentrations compared to other microorganisms (Hu et al. 2021; Olukanni et al. 2019). Its ability to tolerate higher MR concentrations makes it well-suited for the degradation of dyes typically found in industrial wastewater at around 300 mg L−1 (Ceretta et al. 2021).
The adaptability of S. commune 15R-5-F01 to various conditions, including oxygen levels, environmental factors, metal ions, salinity levels, and MR concentrations, underscores its promising potential as a valuable biological agent for industrial wastewater treatment with exceptional reduction efficiency.
Continuous batch culture of S. commune 15R-5-F01 for Methyl Red degradation
Schizophyllum commune 15R-5-F01 demonstrates remarkable capability in degrading MR in continuous batch shaking cultures. Initial exposed to 100 mg L−1 of MR, the fungus achieved an impressive degradation efficiency of 98% within 1 h, near-complete degradation within 3 h (Fig. 2d). Across three consecutive 3-day batches, degradation efficiency remained consistently high, reaching 86.0% by the third batch (Fig. 3). However, it is worth noting that as the number of batches increased, the degradation efficiency experienced a rapid decline. By the six batches, the degradation efficiency dropped significantly to 32% (Fig. 3). This demonstrates the robust degradation ability of S. commune 15R-5-F01, highlighting its potential for treating industrial wastewater containing MR.
Continuous degradation efficiency of S. commune 15R-5-F01 for MR over six consecutive batches. Continuous degradation efficiency of S. commune 15R-5-F01 for MR over six consecutive batches. Each batch culture contained 100 mg L−1 MR and was incubated at 30 °C with agitation at 150 rpm. This figure illustrates the hourly degradation of MR by S. commune 15R-5-F01 across six consecutive batches. On the x-axis, 1–1, 1–2, and 1–3; 2–1, 2–2, and 2–3, and so on represent the 1st, 2nd, and 3rd hours of incubation during the first, second, and subsequent batch cultures. The inset graph shows the degradation efficiency per batch, measured after 3 h of incubation. The mycelium used for each degradation cycle is the recycled mycelium of S. commune 15R-5-F01 from the previous batch, thus accumulating the cyclic degradation amount of S. commune 15R-5-F01 based on the previous MR degradation quantity. The concentration of MR is 100 mg L−1 per batch and all degradation rates were measured after 3 h of degradation by S. commune 15R-5-F01. The inoculation amount of each group was 1 g of wet weight mycelium, with a corresponding dry weight of approximately 90 mg
Moreover, the reuse of S. commune 15R-5-F01 for MR degradation demonstrates its practicality and economic value, offering significant cost reductions in treatment processes. Thus, S. commune 15R-5-F01 emerges as a highly efficient and economically viable biomaterial for addressing MR-contaminated industrial wastewater, holding significant promise in wastewater treatment by providing a sustainable and cost-effective solution.
Biodegradation and bioadsorption ability of Methyl Red by S. commune 15R-5-F01
By investigating the amount of MR reduced in solution by active and inactivated mycelia in solutions with varying concentrations, the findings revealed that as the concentration of MR increased, the total amount of MR removed by active mycelia also increased. At a concentration of 800 mg L−1, the maximum amount of MR biodegradation in solution by active mycelium was 50.25 mg, while inactivated mycelium maintained a stable bioadsorption capacity at approximately 5.16 mg across all concentrations. There was no statistically significant difference (p > 0.05) observed in the maximum amount of bioadsorption with an MR concentration ranging from 100 to 1000 mg L−1 (Fig. 4). This indicates a minimum MR biodegradation capacity of at least 558 mg g−1 dry mycelia and a bioadsorption capacity of 57 mg g–1. The adsorption capacity of MR by S. commune 15R-5-F01 through inactivated mycelium was determined to be only 9.31% of the MR total reduced amount. According to the MR reduced amount of active and inactivated S. commune 15R-5-F01 to different concentrations of MR, we found that biodegradation by active mycelium is the main way for S. commune 15R-5-F01 to remove MR.
Involvement of enzymes in Methyl Red degradation
Enzyme assays revealed that the activities of MnP, LiP, and Lac were generally induced in cultures supplemented with MR compared to the control (without MR) (Fig. 5). Among these enzymes, MnP exhibited the most significant change, with activities reaching 68.38, 123.08 and 225.61U L−1 at 1, 2, and 3 h, respectively, whereas the control showed only 32.21, 37.42, and 39.12 U L−1 at the same time points (Fig. 5). The activities of Lac and LiP also increased in the presence of MR, with Lac reaching 11.73, 4.94, and 2.16 U L−1 and LiP reaching 2.81, 2.13, and 1.22 U L−1, at 1, 2 and 3 h, respectively. In contrast, the control exhibited significantly lower activities for Lac (1.34, 1.35, 1.46 U L−1), and LiP (0.67, 0.78, 0.45 U L−1).
The activities of Lac, MnP, and LiP produced by S. commune 15R-5-F01 during MR degradation. The blue lines indicate enzyme activities of S. commune 15R-5-F01 in the control group (0 mg L−1 MR), while the red lines represent enzyme activities at an MR concentration of 100 mg L−1. The inoculation amount of each group was 1 g of wet weight mycelium, with a corresponding dry weight of approximately 90 mg
Interestingly, when S. commune 15R-5-F01 was cultured in the presence of 100 mg L−1 MR, MnP activity continued to increase over time, while both Lac and LiP reached their peak activities after just 1 h of incubation (Fig. 5). This indicates that the inclusion of MR in the medium had a pronounced impact on the enzymatic activities of S. commune 15R-5-F01.
These findings suggest that the degradation of MR by S. commune 15R-5-F01 involves both oxidative and reductive reactions catalyzed by these enzymes. The significant induction of MnP activity, in particular, implies that MnP plays a crucial role in the breakdown of MR. The elevated activities of Lac and LiP further support the involvement of a complex enzymatic mechanism where multiple enzymes work synergistically to degrade the dye (Alam et al. 2023; Raees et al. 2023). This multi-enzyme approach may enhance the efficiency and speed of MR degradation, highlighting the potential of S. commune 15R-5-F01 in bioremediation applications involving synthetic dyes.
Methyl Red degradation products
Using GC–MS analysis, degradation products of MR by S. commune 15R-5-F01 were identified. Four unique compounds, namely N, N-dimethyl-p-phenylenediamine, 2-aminobenzoic acid, aniline, and N, N-dimethylaniline, were detected in the degradation products, but were absent in control samples and undegraded MR (Table S1 and Fig S1). These compounds belong to a group of dyes called azo dyes, which share a structural similarity with lignin and contain a -N = N- double bond as their primary active site. Azo dyes can undergo symmetric or asymmetric cleavage of covalent bonds at this active site, leading to complete molecular degradation (Ikram et al. 2022).
Based on these findings and relevant literature, a degradation pathway for MR by S. commune 15R-5-F01 was proposed (Fig. 6). The initial step involves the cleavage of the -N = N- bond, resulting in the formation of N,N-dimethyl-p-phenylenediamine (DMPD) and 2-aminobenzoic acid (2-ABA). These intermediates subsequently undergo deamination and decarboxylation processes, yielding aniline and N,N-dimethylaniline.
Phytotoxicity of Methyl Red biodegradation intermediates
The results of plant toxicity test showed that the biotoxicity of S. commune 15R-5-F01 to T. eastivum, O. sativa and V. umbellata was also significantly reduced. Initially, the untreated MR solution significantly inhibited seed germination rate (Fig. 7a). The high toxicity of the untreated 100 mg L−1 MR solution was evident in T. eastivum, O. sativa, and V. umbellata, as demonstrated by shorter plumule (Fig. 7b) and radicle (Fig. 7c) lengths, ultimately leading to a significant decrease in wet weight (Fig. 7d). Notably, radicle growth was more adversely affected than plumule growth, suggesting greater sensitivity of the radicle to dye toxicity (Chen et al. 2019).
Effects of MR (red), MR biodegradation metabolites by S. commune 15R-5-F01 (green), and pure water (blue) solutions on seed germination rate (a), plumule length (b), radicle length (c) and wet weight (d), of T. eastivum, O. sativa, and V. umbellata. The supernatant obtained after degradation for 3 h, along with deionized water and a 100 mg L−1 MR solution as controls, was filtered through a 0.22 μm millipore filter and used to spray 10 seeds placed on filter paper in petri dishes. The dishes were incubated at 30 °C, and after 6 days, the germination rate, radicle and germ length, and wet weight of seeds were measured
However, following degradation by S. commune 15R-5-F01, the phytotoxicity of the MR solution was substantially mitigated. Post-treatment, seed germination rates showed a significant increase (Fig. 7a), with T. eastivum and V. umbellata seeds achieving a 100% germination rate, comparable to the blank control (water), while O. sativa seeds exhibited a slightly lower rate of 94%. Additionally, both plumule (Fig. 7b) and radicle (Fig. 7c) lengths experienced considerable enhancement, albeit still slightly less than the blank control group. Remarkably, seeds exposed to MR degradation metabolites demonstrated growth patterns similar to those treated with pure water. The superior impact on radicle development over plumule growth further highlights the radicle's heightened sensitivity, not only to MR toxicity but also to its degradation products. These findings underscore that the application of S. commune 15R-5-F01 in culture medium poses minimal toxicity to plant growth, particularly in improving seed germination rates. Previous studies have shown that MR can be degraded into two substances, DMPD and 2-ABA and it has been found that these two substances do not exhibit toxicity towards Sorghum vulgare, Phaseolus mungo and Vigna radiata (Ikram et al. 2022; Jayapal et al. 2018; Waghmode et al. 2019). This study demonstrated that the phytotoxicity of MR solution, degraded by S. commune 15R-5-F01, was effectively eliminated in the three agricultural crops: T. eastivum, O. sativa and V. umbellata. As a result, the impact on the natural environment and agricultural production is significantly reduced. This suggests that S. commune 15R-5-F01 represents an eco-friendly biomaterial for treating industrial wastewater contaminated with MR, offering substantial potential for future environmental applications.
Conclusion
Our study highlights the exceptional adaptability of fungi in the subseafloor environment, with a specific focus on S. commune 15R-5-F01 as a promising candidate for bioremediation. This fungus demonstrates outstanding proficiency in degrading MR, achieving degradation rates exceeding 96% across various conditions, including aerobic and anaerobic environments. Its ability to withstand pH variations, metal ions, and salinity further enhances its potential applications. Moreover, a key advantage of S. commune 15R-5-F01 is its effective utilization of mycelium in MR degradation, minimizing adsorption effects and ensuring active enzymatic breakdown. Enzymes like MnP, LiP, and Lac play essential roles in converting MR into non-toxic metabolites, showcasing the fungus's effectiveness in wastewater treatment applications. However, challenges such as initial cultivation costs and industrial scalability necessitate further investigation to facilitate the transition of S. commune 15R-5-F01 from laboratory success to practical industrial use. Therefore, future research endeavors will concentrate on several critical areas, such as exploring the genetic underpinnings of S. commune 15R-5-F01's MR degradation pathways to enhance its biodegradation capabilities through enzyme genetic engineering; developing cost-effective techniques for large-scale cultivation and optimizing production processes to improve economic feasibility; integrating cutting-edge materials and technologies (e.g., nanoparticles, immobilization matrices) to enhance stability and efficiency in industrial wastewater treatment; and conducting field trials to validate laboratory findings and evaluate S. commune 15R-5-F01's performance under real-world environmental conditions.
Data availability
The data underlying this article are available in the article and its online supplementary material.
References
Alam R, Mahmood RA, Islam S, Ardiati FC, Solihat NN, Alam MB, Lee SH, Yanto DHY, Kim S (2023) Understanding the biodegradation pathways of azo dyes by immobilized white-rot fungus, Trametes hirsuta D7, using UPLC-PDA-FTICR MS supported by in silico simulations and toxicity assessment. Chemosphere 313:137505. https://doi.org/10.1016/j.chemosphere.2022.137505
Al-Najar B, Younis A, Hazeem L, Sehar S, Rashdan S, Shaikh MN, Albuflasa H, Hankins NP (2021) Thermally induced oxygen related defects in eco-friendly ZnFe2O4 nanoparticles for enhanced wastewater treatment efficiencies. Chemosphere 288:132525. https://doi.org/10.1016/j.chemosphere.2021.132525
An XJ, Cheng Y, Li NJ, Zhang SL, LiW W, Zhang QH (2023) Green and sustainable approach for decoloration and detoxification of azo dye by bacterial-mediated thermo-halotolerant dye-decolorizing peroxidase (DyP). Process Biochem 130:334–346. https://doi.org/10.1016/j.procbio.2023.03.037
Asses N, Ayed L, Hkiri N, Hamdi M (2018) Congo Red decolorization and detoxification by Aspergillus niger: Removal mechanisms and dye degradation pathway. BioMed Res Int 2018:3049686. https://doi.org/10.1155/2018/3049686
Bankole PO, Adekunle AA, Govindwar SP (2018) Enhanced decolorization and biodegradation of acid red 88 dye by newly isolated fungus, Achaetomium strumarium. J Environ Chem Eng 6(2):1589–1600. https://doi.org/10.1016/j.jece.2018.01.069
Ceretta MB, Nercessian D, Wolski EA (2021) Current trends on role of biological treatment in integrated treatment technologies of textile wastewater. Front Microbiol 12:651025. https://doi.org/10.3389/fmicb.2021.651025
Chau TP, Bulgariu L, Saravanan M, Rajkumar R, Chinnathambi A, Salmen SH, Jhanani GK (2023) Bioremediation efficiency of free and immobilized form of Aspergillus niger and Aspergillus tubigenesis biomass on tannery effluent. Environ Res 231(15):116257. https://doi.org/10.1016/j.envres.2023.116275
Chen SH, Cheow YL, Ng SL, Ting ASY (2019) Biodegradation of triphenylmethane dyes by non-white rot fungus Penicillium simplicissimum: enzymatic and toxicity studies. Int J Environ Res 13:273–282. https://doi.org/10.1007/s41742-019-00171-2
Gautam A, Kumar A, Bharti AK, Dutt D (2018) Rice straw fermentation by Schizophyllum commune ARC-11 to produce high level of xylanase for its application in pre-bleaching. J Genet Eng Biotechnol 16:693–701. https://doi.org/10.1016/j.jgeb.2018.02.006
Góralczyk-Bińkowska A, Długoński A, Bernat P, Długoński J, Jasińska A (2021) Environmental and molecular approach to dye industry waste degradation by the ascomycete fungus Nectriella pironii. Sci Rep 11:23829. https://doi.org/10.1038/s41598-021-03446-x
Guo G, Tian F, Zhao Y, Tang MM, Liu WJ, Liu C, Xue SW, Kong WN, Sun YM, Wang SW (2019) Aerobic decolorization and detoxification of acid scarlet GR by a newly isolated salt-tolerant yeast strain Galactomyces geotrichum GG. Int Biodeter Biodegrad 145:104818. https://doi.org/10.1016/j.ibiod.2019.104818
Guo G, Hao JX, Tian F, Liu C, Ding KQ, Zhang C, Yang F, Xu J (2020) Decolorization of Metanil Yellow G by a halophilic alkalithermophilic bacterial consortium. Bioresource Technol 316:123923. https://doi.org/10.1016/j.biortech.2020.123923
Guo G, Liu C, Hao JX, Tian F, Guan ZB (2021) Development and characterization of a halo-thermophilic bacterial consortium for decolorization of azo dye. Chemosphere 272:129916. https://doi.org/10.1016/j.chemosphere.2021.129916
Hamdi S, Allala F, Mechri S, Bouacem K, Rekik H, Hacene H, Jaouadi B, Roes-Hill ML, Jaouadi NZ (2022) Biochemical and molecular characterization of a new heme peroxidase from Aspergillus niger CTM10002, and its application in textile reactive dye decolorization. Int J Biol Macromol 121:619–634. https://doi.org/10.1016/j.procbio.2022.08.007
Haque MM, Haque MA, Mosharaf MK, Islam MS, Islam MM, Hasan M, Molla AH, Haque MA (2022) Biofilm-mediated decolorization, degradation and detoxification of synthetic effluent by novel biofilm-producing bacteria isolated from textile dyeing effluent. Environ Pollut 314:120237. https://doi.org/10.1016/j.envpol.2022.120237
He XL, Song C, Li YY, Wang N, Xu X, Han X, Wei DS (2018) Efficient degradation of Azo dyes by a newly isolated fungus Trichoderma tomentosum under non-sterile conditions. Ecotox Environ Safe 150:232–239. https://doi.org/10.1016/j.ecoenv.2017.12.043
Hu CY, Cheng HY, Yao XM, Li LZ, Liu HW, Guo WQ, Yan LS, Fu JL (2021) Biodegradation and decolourization of methyl red by Aspergillus versicolor LH1. Prep Biochem Biotech 51(7):642–649. https://doi.org/10.1080/10826068.2020.1848868
Huang X, Liu X, Xue YR, Pan BC, Xiao L, Wang S, Lever MA, Hinrichs KU, Inagaki F, Liu CH (2022) Methane production by facultative anaerobic wood-rot fungi via a new halomethane-dependent pathway. Microbiol Spectr 10:e0170022. https://doi.org/10.1128/spectrum.01700-22
Ikram M, Naeem M, Zahoor M, Rahim A, Hanafiah MM, Oyekanmi AA, Shah AB, Mahnashi MH, Ali AA, Jalal NA, Bantun F, Sadiq A (2022) Biodegradation of azo dye Methyl Red by Pseudomonas aeruginosa: Optimization of process conditions. Int J Environ Res Publ Health 19:9962. https://doi.org/10.3390/ijerph19169962
Jasińska A, Paraszkiewicz K, Sip A, Długoński J (2015) Malachite green decolorization by the filamentous fungus Myrothecium roridum—mechanistic study and process optimization. Bioresour Technol 194:43–48. https://doi.org/10.1016/j.biortech.2015.07.008
Jayapal M, Jagadeesan H, Shanmugam M, Perinba DJ, hobana S (2018) Sequential anaerobic-aerobic treatment using plant microbe integrated system for degradation of azo dyes and their aromatic amines by-products. J Hazard Mater 354(18):231–243. https://doi.org/10.1016/j.jhazmat.2018.04.050
Karm SK, Upadhyay A, Kumar A (2022) Biomonitoring of endosulfan toxicity in human. Biocell 46(7):1771–1777. https://doi.org/10.32604/biocell.2022.018845
Kumar S, Neeraj MVK, Karn SK (2018) Biodegradation of phenol by free and immobilized Candida tropicalis NPD1401. Afr J Biotechnol 17(3):57–64. https://doi.org/10.5897/AJB2017.15906
Kumar A, Singh AK, Bilal M, Chandra R (2022) Extremophilic ligninolytic enzymes: Versatile biocatalytic tools with impressive biotechnological potential. Catal Lett 152:2302–2326. https://doi.org/10.1007/s10562-021-03800-8
Kurade MB, Waghmode TR, Govindwar SP (2011) Preferential biodegradation of structurally dissimilar dyes from a mixture by Brevibacillus laterosporus. J Hazard Mater 192:1746–1755. https://doi.org/10.1016/j.jhazmat.2011.07.004
Lellis B, Fávaro-Polonio CZ, Pamphile JA, Polonio JC (2019) Effects of textile dyes on health and the environment and bioremediation potential of living organisms. Biotechnol Res Innov 3:275–290. https://doi.org/10.1016/j.biori.2019.09.001
Liu CH, Huang X, Xie TN, Duan N, Xue YR, Zhao TX, Lever MA, Hinrichs KU, Inagaki F (2017) Exploration of cultivable fungal communities in deep coal-bearing sediments from approximately 1.3 to 2.5 km below the ocean floor. Environ Microbiol 19(2):803–818. https://doi.org/10.1111/1462-2920.13653
Liu X, Huang X, Chu C, Xu H, Wang L, Xue YR, Arifeenul MZ, Inagaki F, Liu CH (2022) Genome, genetic evolution, and environmental adaptation mechanisms of Schizophyllum commune in deep subseafloor coal-bearing sediments. iScience 25:104417. https://doi.org/10.1016/j.isci.2022.104417
Maniyam MN, Ibrahim AL, Cass AEG (2020) Decolourization and biodegradation of azo dye methyl red by Rhodococcus strain UCC 0016. Environ Technol 41:71–85. https://doi.org/10.1080/09593330.2018.1491634
Marvi-Mashhadi A, Sharifmoghadam MR, Goharimanesh M, Marvi-Mashhadi M, Dehghan H, Bahreini M (2022) Methyl red biodegradation based on Taguchi method by two novel bacteria. Int J Environ Sci Technol 19(3):1357–1368. https://doi.org/10.1007/s13762-021-03264-8
Masarbo RS, Karegoudar TB (2022) Decolourisation of toxic azo dye Fast Red E by three bacterial strains: process optimisation and toxicity assessment. Int J Environ an Ch 102:2686–2696. https://doi.org/10.1080/03067319.2020.1759048
Olukanni O, Awotula A, Osuntoki A, Govindwar S (2019) Influence of redox mediators and media on methyl red decolorization and its biodegradation by Providencia rettgeri. SN Appl Sci 1:697. https://doi.org/10.1007/s42452-019-0668-0
Praveen S, Jegan J, Bhagavathi PT, Gokulan R, Bulgariu L (2022) Biochar for removal of dyes in contaminated water: an overview. Biochar 4:10. https://doi.org/10.1007/s42773-022-00131-8
Raees A, Bhatti HN, Alshehri S, Aslam F, Al-Fawzan FF, Alissa SA, Iqbal M, Nazir A (2023) Adsorption potential of Schizophyllum commune white rot fungus for degradation of reactive dye and condition optimization: a thermodynamic and kinetic study. Adsorpt Sci Technol 2023:1–12. https://doi.org/10.1155/2023/4725710
Routoula E, Patwardhan SV (2020) Degradation of anthraquinone dyes from effluents: a review focusing on enzymatic dye degradation with industrial potential. Environ Sci Technol 54:647–664. https://doi.org/10.1021/acs.est.9b03737
Saratale RG, Saratale GD, Chang JS, Govindwar SP (2011) Bacterial decolorization and degradation of azo dyes: A review. J Taiwan Inst Chem E 42:138–157. https://doi.org/10.1016/j.jtice.2010.06.006
Sehar S, Hazeem LJ, Naz I, Rehman A, Sun W, Alhewairini SS, Thani ASB, Akhter MS, Younis A (2021) Facile synthesis of zero valent sulfur nanoparticles for catalytic detoxification of hexavalent chromium, cytotoxicity against microalgae and ultraviolet protection properties. Korean J Chem Eng 38:2294–2303. https://doi.org/10.1007/s11814-021-0868-3
Shi YQ, Yang ZL, Xing L, Zhang XZ, Li XG, Zhang DH (2021) Recent advances in the biodegradation of azo dyes. World J Microb Biot 37:137–137. https://doi.org/10.1007/s11274-021-03110-6
Singh G, Dwivedi SK (2020) Decolorization and degradation of Direct Blue-1 (Azo dye) by newly isolated fungus Aspergillus terreus GS28, from sludge of carpet industry. Environ Technol Innov 18:100751. https://doi.org/10.1016/j.eti.2020.100751
Solís M, Solís A, Pérez HI, Manjarrez N, Flores M (2012) Microbial decolouration of azo dyes: a review. Process Biochem 47:1723–1748. https://doi.org/10.1016/j.procbio.2012.08.014
Telke AA, Kalyani DC, Dawkar VV, Govindwar SP (2009) Influence of organic and inorganic compounds on oxidoreductive decolorization of sulfonated azo dye CI reactive orange. J Hazard Mater 172(1):298–309. https://doi.org/10.1016/j.jhazmat.2009.07.008
ulArifeen MZ, Ma YN, Wu TS, Chu C, Liu X, Jiang JP, Li DX, Xue YR, Liu CH (2022) Anaerobic biodegradation of polycyclic aromatic hydrocarbons (PAHs) by fungi isolated from anaerobic coal-associated sediments at 2.5 km below the seafloor. Chemosphere 303:135062. https://doi.org/10.1016/j.chemosphere.2022.135062
Waghmode TR, Kurade MB, Sapkal RT, Bhosale CH, Jeon BH, Govindwar SP (2019) Sequential photocatalysis and biological treatment for the enhanced degradation of the persistent azo dye methyl red. J Hazard Mater 371:115–122. https://doi.org/10.1016/j.jhazmat.2019.03.004
Xu FJ, Chen HZ, Li ZH (2001) Solid-state production of lignin peroxidase (LiP) and manganese peroxidase (MnP) by Phanerochaete chrysosporium using steam-exploded straw as substrate. Bioresour Technol 80:149–151. https://doi.org/10.1016/S0960-8524(01)00082-7
Younis A, Loucif A (2021) Defects mediated enhanced catalytic and humidity sensing performance in ceria nanorods. Ceram Int 47:15500–15507. https://doi.org/10.1016/j.ceramint.2021.02.117
Acknowledgements
This work was supported by the Science and Technology Innovation Program of Jiangsu Province (no. BK20220036) and the National Natural Science Foundation of China (nos. 42273077, 41973073, 91951121, 41773083).
Author information
Authors and Affiliations
Contributions
H.X. responsible for the design of experiments, data analysis and wrote the first draft of this paper. H.Y.Z. helped with data analysis and edited the manuscript. C.H.L conceived the study and edited the manuscript.
Corresponding author
Ethics declarations
Conflict of interest
We declare that we have no financial and personal relationships with other people or organizations that can inappropriately influence our work, there is no professional or other personal interest of any nature or kind in any product, service and/or company that could be construed as influencing the position presented in, or the review of, the manuscript entitled.
Rights and permissions
Springer Nature or its licensor (e.g. a society or other partner) holds exclusive rights to this article under a publishing agreement with the author(s) or other rightsholder(s); author self-archiving of the accepted manuscript version of this article is solely governed by the terms of such publishing agreement and applicable law.
About this article
Cite this article
Xu, H., Zheng, HY. & Liu, CH. Methyl Red degradation by a subseafloor fungus Schizophyllum commune 15R-5-F01: efficiency, pathway, and product toxicity. 3 Biotech 14, 202 (2024). https://doi.org/10.1007/s13205-024-04037-z
Received:
Accepted:
Published:
DOI: https://doi.org/10.1007/s13205-024-04037-z